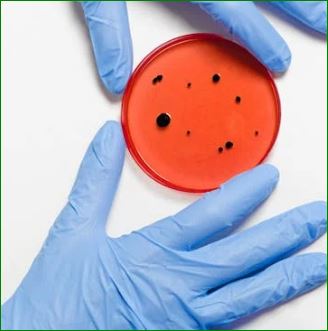
Virus

치사율 70% 치명적인 원숭이 B 바이러스, 이렇게 국내에 들어왔다!
코로나19 팬데믹이 한창이던 2020년, 한국생명공학연구원 산하 영장류자원지원센터에서 연구용 원숭이 340마리를 캄보디아에서 들여왔다.
그런데 이 중 무려 200마리 이상이 '원숭이 B 바이러스' 항체 양성 반응을 보였다.
이 바이러스가 뭔고 하니? 사람한테 옮으면 중추신경을 파고들어 뇌염을 일으키고, 치사율이 무려 70%에 달하는 무시무시한 녀석이다.
💀 감염 의심? 그래도 추가 검사는 NO!
그럼 원숭이들이 진짜 바이러스에 감염된 건지 확인해야 하지 않겠나? 그런데 센터 측은 PCR 같은 추가 검사는커녕, 검역본부나 환경청에도 알리지 않았다.
"항체 검사만으로는 감염 여부를 확정할 수 없다"는 이유였다.

이게 무슨 말장난인가? 바이러스가 정말 있는지 확인하는 게 그쪽 일이 아닌가? 심지어 이 원숭이들은 이후 정읍, 오창, 성남 등 국내 여러 지역을 떠돌며 사육되었고, 7개월 동안 적절한 격리 조치 없이 방치되었다.
🚨 1년 뒤에도 또 원숭이를 들여왔다고?
이 사건이 벌어진 지 1년 후, 같은 센터에서 같은 업체를 통해 다시 원숭이 340마리를 들여왔다. 그리고 이번에도 50마리 이상에서 B 바이러스 항체가 검출됐다.
하지만 이번엔 감염 의심 원숭이들을 반품하지 않고 전부 안락사시켰다.
그런데 왜? 이유는 간단했다. 전년도처럼 반품하려 했는데, 이번엔 환경청에서 제동을 걸었기 때문. 반품이 어려워지자, 그제야 "바이러스 양성"이라고 신고하고 안락사하는 방향으로 선회한 것이다.

검역은 무슨 일로 뚫렸을까?
이렇게 치명적인 바이러스가 국내로 들어오는 걸 검역 단계에서 걸러내야 하는 거 아닌가? 하지만 농림축산검역본부는 캄보디아 측이 "B 바이러스가 없다"는 서류만 확인하고 그대로 들여보냈다.
이쯤 되면 궁금해진다. 도대체 우리나라 검역 기준에는 원숭이 B 바이러스가 포함되어 있긴 한 걸까? 아니다. 이 바이러스는 질병관리청이 고위험 병원체로 지정해 놓긴 했지만, 가축전염병법이나 야생생물법 등 원숭이 수입·사육을 관리하는 법에는 포함되지 않았다.
즉, "관리 대상이 아니라서 검사도 안 했다"는 황당한 상황이 벌어진 것이다.
우리나라 감염병 관리 시스템, 이대로 괜찮나?
이번 사건을 보면, 치명적인 바이러스가 포함된 원숭이들이 쉽게 국내에 들어올 수 있고, 추가 검사 없이 여기저기 옮겨 다닐 수 있다는 사실이 드러났다.
검역 체계는 허점투성이, 연구기관의 대응은 미흡, 관계 당국의 책임감은 글쎄…?
JMS 정명석 피해자에서 방력신의 신부로! 메이플의 행복한 새 출발
JMS 정명석 피해자에서 방력신의 신부로! 메이플의 행복한 새 출발 JMS(기독교복음선교회) 교주 정명석의 성범죄를 고발했던 피해자 메이플이 당당한 신부가 되어 인생의 새 출발을 알렸다! 그
krush.co.kr
이제라도 인수공통감염병 관리를 법적으로 정비하고, 관련 기관들이 서로 핑퐁게임 하는 걸 막아야 한다.
원숭이 B 바이러스가 국내에서 퍼지는 일이 없도록 철저한 대비가 필요하지 않을까?